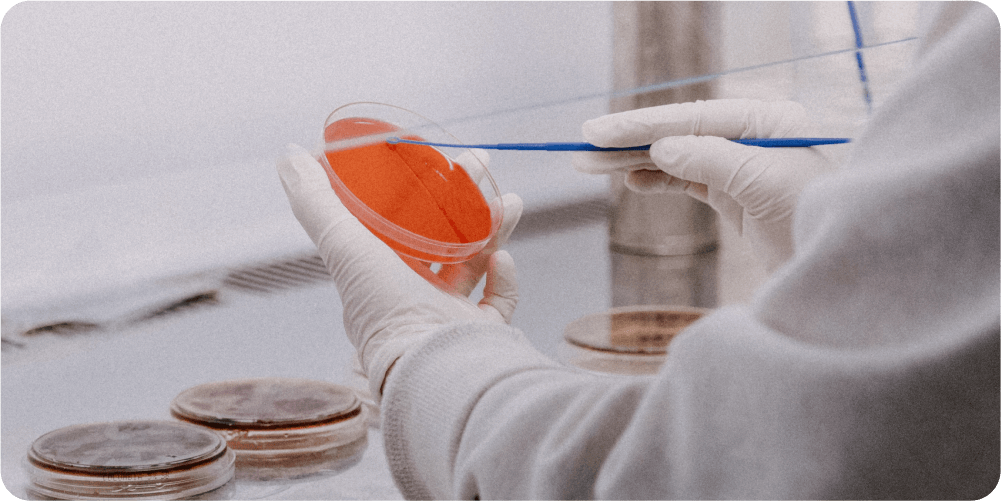
Учёный в перчатках работает в лаборатории, держа чашку Петри с красной питательной средой и используя синий инструмент. На столе видны другие чашки.

Участие в клинических исследованиях
Ежедневно во всем мире проводится несколько тысяч испытаний новых препаратов и методов лечения. И у тебя есть возможность принять участие в одном из них, при условии соответствия диагноза и общего состояния.
Все клинические испытания проводятся официально с участием Министерства здравоохранения. Посмотреть, какие испытания проводятся в мире прямо сейчас и в каких можно принять участие в Беларуси, можно по этой ссылке:
https://www.clinicaltrials.gov/ct2/search/advanced.
Иногда участников с подходящими параметрами найти непросто, поэтому берут и иностранных участников и оплачивают транспортные расходы для них. Если ты видишь подходящее исследование в другой стране, имеет смысл написать напрямую в клинику, где проводится исследование, и выслать им свои медицинские документы.
Клиническое исследование проводится в соответствии с планом исследования, известным как протокол. Протокол разработан, чтобы ответить на конкретные вопросы исследования и защитить здоровье участников. Он содержит следующую информацию:
- Причина проведения исследования
- Кто может участвовать в исследовании (критерии отбора)
- Необходимое количество участников
- График анализов, процедур или лекарств и их дозировки
- Продолжительность исследования
- Какая информация будет собираться об участниках
Кто может участвовать в клиническом исследовании?
В клинических исследованиях есть стандарты, определяющие, кто может участвовать. Эти стандарты называются критериями приемлемости и перечислены в протоколе. Некоторые исследования ищут участников, у которых есть заболевания или состояния, которые будут изучаться, другие исследования ищут здоровых участников, а некоторые исследования ограничиваются заранее определенной группой людей, которых исследователи просят принять участие.
В клинических исследованиях есть стандарты, определяющие, кто может участвовать. Эти стандарты называются критериями приемлемости и перечислены в протоколе. Некоторые исследования ищут участников, у которых есть заболевания или состояния, которые будут изучаться, другие исследования ищут здоровых участников, а некоторые исследования ограничиваются заранее определенной группой людей, которых исследователи просят принять участие.
Право на участие. Факторы, которые позволяют кому-либо участвовать в клиническом исследовании, называются критериями включения, а факторы, которые дисквалифицируют кого-либо из участия, называются критериями исключения. Они основаны на таких характеристиках, как возраст, пол, тип и стадия заболевания, история предыдущего лечения и другие медицинские состояния.
Как защищены участники?
Информированное согласие — это процесс, используемый исследователями для предоставления потенциальным и зарегистрированным участникам информации о клиническом исследовании. Эта информация помогает людям решить, хотят ли они участвовать или продолжать участвовать в исследовании. Процесс информированного согласия предназначен для защиты участников и должен предоставить достаточно информации, чтобы человек понял риски, потенциальные преимущества и альтернативы исследованию. Подписание документа и предоставление согласия не являются договором. Участники могут отказаться от участия в исследовании в любое время, даже если оно еще не закончено.
Информированное согласие — это процесс, используемый исследователями для предоставления потенциальным и зарегистрированным участникам информации о клиническом исследовании. Эта информация помогает людям решить, хотят ли они участвовать или продолжать участвовать в исследовании. Процесс информированного согласия предназначен для защиты участников и должен предоставить достаточно информации, чтобы человек понял риски, потенциальные преимущества и альтернативы исследованию. Подписание документа и предоставление согласия не являются договором. Участники могут отказаться от участия в исследовании в любое время, даже если оно еще не закончено.
Принимать решение об участии в любом случае только тебе. Но мы бы хотели развеять несколько страхов, о которых ты могла подумать.
Кто-то считает, что страшно быть подопытным кроликом. Но на практике — широкомасштабные клинические испытания проводятся на самом последнем этапе, когда механизм действия лекарства хорошо изучен. И по сути — на тебе не столько тестируют препарат, сколько собирают необходимую медицинскую статистику для патентования. Это самые современные и самые качественные препараты (одинаковые во всех странах для достоверности исследований).
Есть простая логика — фармкомпании заинтересованы в максимально положительных результатах и сделают для этого всё. Они (фармкомпании) платят Минздраву за проведение исследований с целью обеспечить условия для хорошего наблюдения за пациентом, предоставляют не только химиопрепараты, но иногда и лекарства для устранения побочек. Жаль только, что в исследования не попадёшь по “блату”. Необходимо четкое попадание в стандарты, за которыми следят независимые европейские лаборатории. Что в целом и обосновано, потому что эффект будет позитивным при лечении того, для чего предназначен препарат.
К вопросу финансов: при попадании в программу клинических исследований всё (в рамках протокола) оплачивается фармой. Иногда подходящих пациентов совсем немного – и компании оплачивают даже транспортные расходы, даже при поездках в другие страны.

